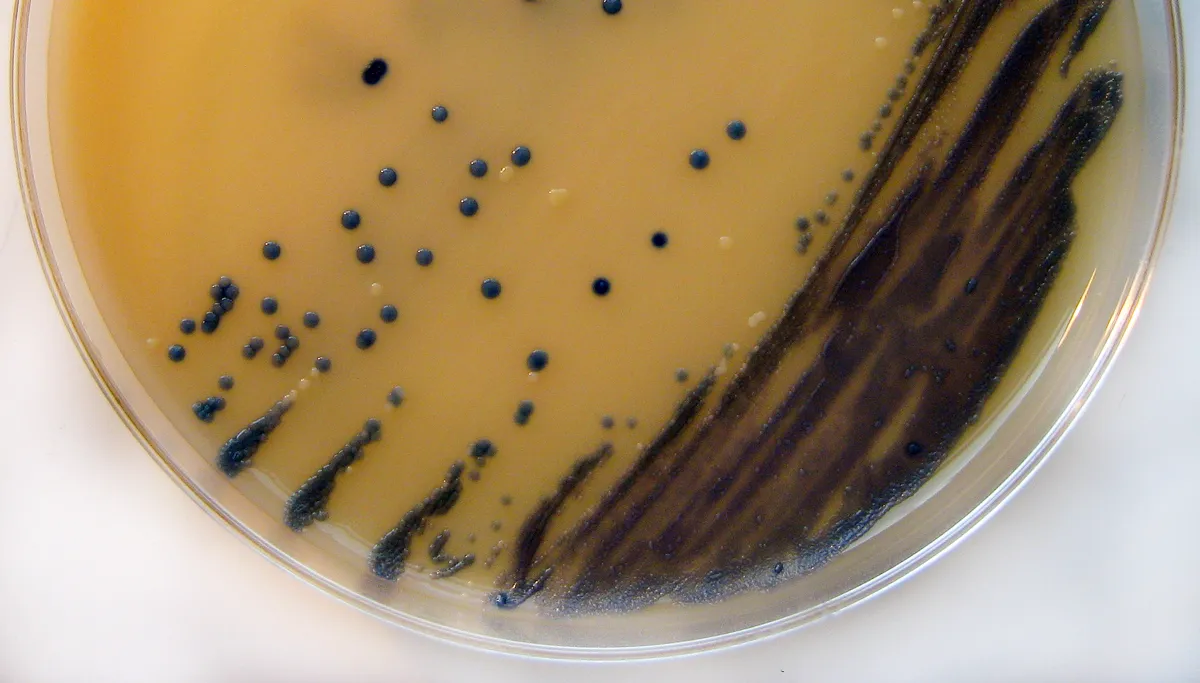
bacterile groei mrsa petrischaal

Zuyd Hogeschool trekt kar bij onderzoek naar antimicrobiële coatings
30 nov 2016, 9:51 • Nieuws
Nathan Reading on Flickr Nathan R. on twitter (Flickr) [CC BY 2.0] via Wikimedia Commons
Sinds kort wordt op grote schaal onderzoek gedaan naar het gebruik van antimicrobiële (nano-)coatings op het voorkomen van infecties in zorginstellingen.
Meer dan 60 hogescholen, universiteiten, onderzoeksinstituten en bedrijven uit 29 Europese landen hebben afgesproken om daar samen onderzoek naar te doen en hebben hun krachten gebundeld in het AMiCI-consortium (Anti-Microbial Coating Innovations to prevent infectious disease).
Een van de belangrijkste voortrekkers van het project is Zuyd Hogeschool. Dr. Francy Crijns, senior docent-onderzoeker bij Zuyd Hogeschool in Heerlen, is voorzitter van het AMiCI-consortium.
Dat dit onderzoek van groot belang is blijkt uit het feit dat jaarlijks naar schatting zo'n 4 miljoen mensen een zorggerelateerde infectie oplopen, zoals bijvoorbeeld een besmetting met de MRSA-bacterie. Door toepassing van antimicrobiële (nano-)coatings wil men bacteriële groei, de ontwikkeling van multiresistente bacteriën en het infectiegevaar in zorgomgevingen tegengaan. Voor het onderzoek naar de mogelijkheden op dat terrein is multidisciplinaire en internationale samenwerking nodig. Zo moet worden onderzocht hoe en welke antimicrobiële materialen kunnen worden gemaakt, wat hun effectiviteit is en welke risico's zijn verbonden aan de toepassing van deze coatings en hoe onderhoud en reiniging moeten plaatsvinden.
Dit AMiCI-onderzoek sluit naadloos aan bij diverse lectoraten en twee van de vier zwaartepunten van Zuyd Hogeschool ‒ Innovatieve zorg en technologie, en Life sciences and materials ‒ en is een nieuw succes voor het team dat onderzoek doet naar antimicrobiële coatings. Verder is er een rol weggelegd voor onder andere Chemelot Innovation and Learning Labs (CHILL), Expertisecentrum Innovatieve Zorg en Technologie (EIZT), Maastricht Universitair Medisch Centrum, Saxion en enkele zorginstellingen, zoals de Zuyderland-ziekenhuizen in Heerlen en Geleen en het VieCuri in Venlo.
De genoemde ziekenhuizen starten komend jaar met een proef waarbij enkele ziekenhuiskamers worden voorzien van antimicrobiële coatings.
Loading articles...
Loading





